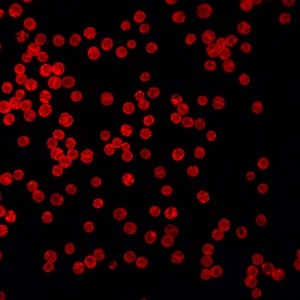
Icon representing the file Symbiodinium-enriched RNA extraction from Aiptasia holobiont

Jul 22, 2018
Getting started with the Aiptasia-Symbiodinium Model System

- Aiptasia Model1
- 1Oregon State University
- reefgenomics
- Aiptasia Symbiodiniaceae Model System

Collection Citation: Aiptasia Model 2018. Getting started with the Aiptasia-Symbiodinium Model System. protocols.io https://dx.doi.org/10.17504/protocols.io.rj4d4qw
License: This is an open access collection distributed under the terms of the Creative Commons Attribution License, which permits unrestricted use, distribution, and reproduction in any medium, provided the original author and source are credited
Protocol status: Working
We use these protocols in the EDGE labs and they are working
Created: July 10, 2018
Last Modified: July 22, 2018
Collection Integer ID: 13660
Keywords: symbiodinium model system, symbiodinium, dinoflagellate symbiosis nsf grant, genomics tool, aiptasia, dna, rna
Abstract
A collection of protocols released as part of the IOS EDGE: Functional-genomics tools for Cnidarian-dinoflagellate symbiosis NSF grant (#1645164).
Lead PIs:
Virginia Weis, Oregon State University
Mauricio Rodriguez-Lanetty, Florida International University
Matthew DeGennaro, Florida International University
Arthur Grossman, Carnegie Institution for Science
John Pringle, Stanford University
Protocols for getting started w/ the Aiptasia-Symbiodinium Model System:
-General husbandry and culturing of Aiptasia and Symbiodinium in the laboratory
-DNA, RNA, and protein extraction
-Embedding animals for microscopy
-Genotyping
Troubleshooting
Files
Protocol


Name
General Aiptasia husbandry - Weis Lab
Version 1

Jason S PresnellOregon State University
Protocol


Name
General Aiptasia husbandry - Pringle lab
Version 1

Christian CR RenickeStanford University - Genetics
Protocol


Name
Cold-shock protocol to bleach Aiptasia
Version 1

Christian CR RenickeStanford University - Genetics
Protocol


Name
Menthol protocol to bleach Aiptasia
Version 1

Aiptasia ModelOregon State University
Protocol


Name
Culturing Symbiodinium
Version 1

Tingting XiangUniversity of California, Riverside
Protocol


Name
Isolation of axenic Symbiodinium cultures
Version 1

Tingting XiangUniversity of California, Riverside
Protocol


Name
Colonization of aposymbiotic Aiptasia with Symbiodinium
Version 1

Christian CR RenickeStanford University - Genetics
Protocol


Name
Aiptasia spawning and embryo/larvae handling - Weis Lab
Version 1

Jason S PresnellOregon State University
Protocol


Name
Aiptasia spawning and embryo/larvae handling - Pringle Lab
Version 1

Christian CR RenickeStanford University - Genetics
Protocol


Name
Embedding living larvae in low-melting agarose for imaging and recovery thereafter
Version 1

Christian CR RenickeStanford University - Genetics
Protocol


Name
Preparing small, live Aiptasia polyps for confocal microscopy
Version 1

Jason S PresnellOregon State University
Protocol


Name
Symbiodinium / Aiptasia cell pop (crude lysis for PCR template)
Version 1

Anthony Bellantuono
Protocol


Name
2×CTAB Protocol for Isolation of predominantly Symbiodinium DNA from symbiotic anemones
Version 1

Christian CR RenickeStanford University - Genetics
Protocol


Name
2×CTAB Protocol for (simultaneous) DNA Isolation from Aiptasia and Symbiodinium
Version 1

Christian CR RenickeStanford University - Genetics
Protocol


Name
2×CTAB Protocol for predominantly host DNA isolation from symbiotic Aiptasia
Version 1

Christian CR RenickeStanford University - Genetics
Protocol


Name
DNA Extraction from Symbiodinium Cultures
Version 1

Tingting XiangUniversity of California, Riverside
Protocol


Name
Using genomic SCAR markers for genotyping Aiptasia strains
Version 1

Christian CR RenickeStanford University - Genetics
Protocol

Name
Symbiodinium-enriched RNA extraction from Aiptasia holobiont
Version 1

Anthony Bellantuono
Protocol


Name
Symbiodinium cp23S RFLP and sequence analysis
Version 1

Christian CR RenickeStanford University - Genetics
Protocol


Name
Protein extraction from Aiptasia
Version 1

Jason S PresnellOregon State University